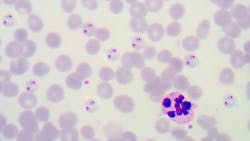
678925b89e95495de2ad1660 Dreamstime Xxl 66537811 678925b89e95495de2ad1660 Dreamstime Xxl 66537811
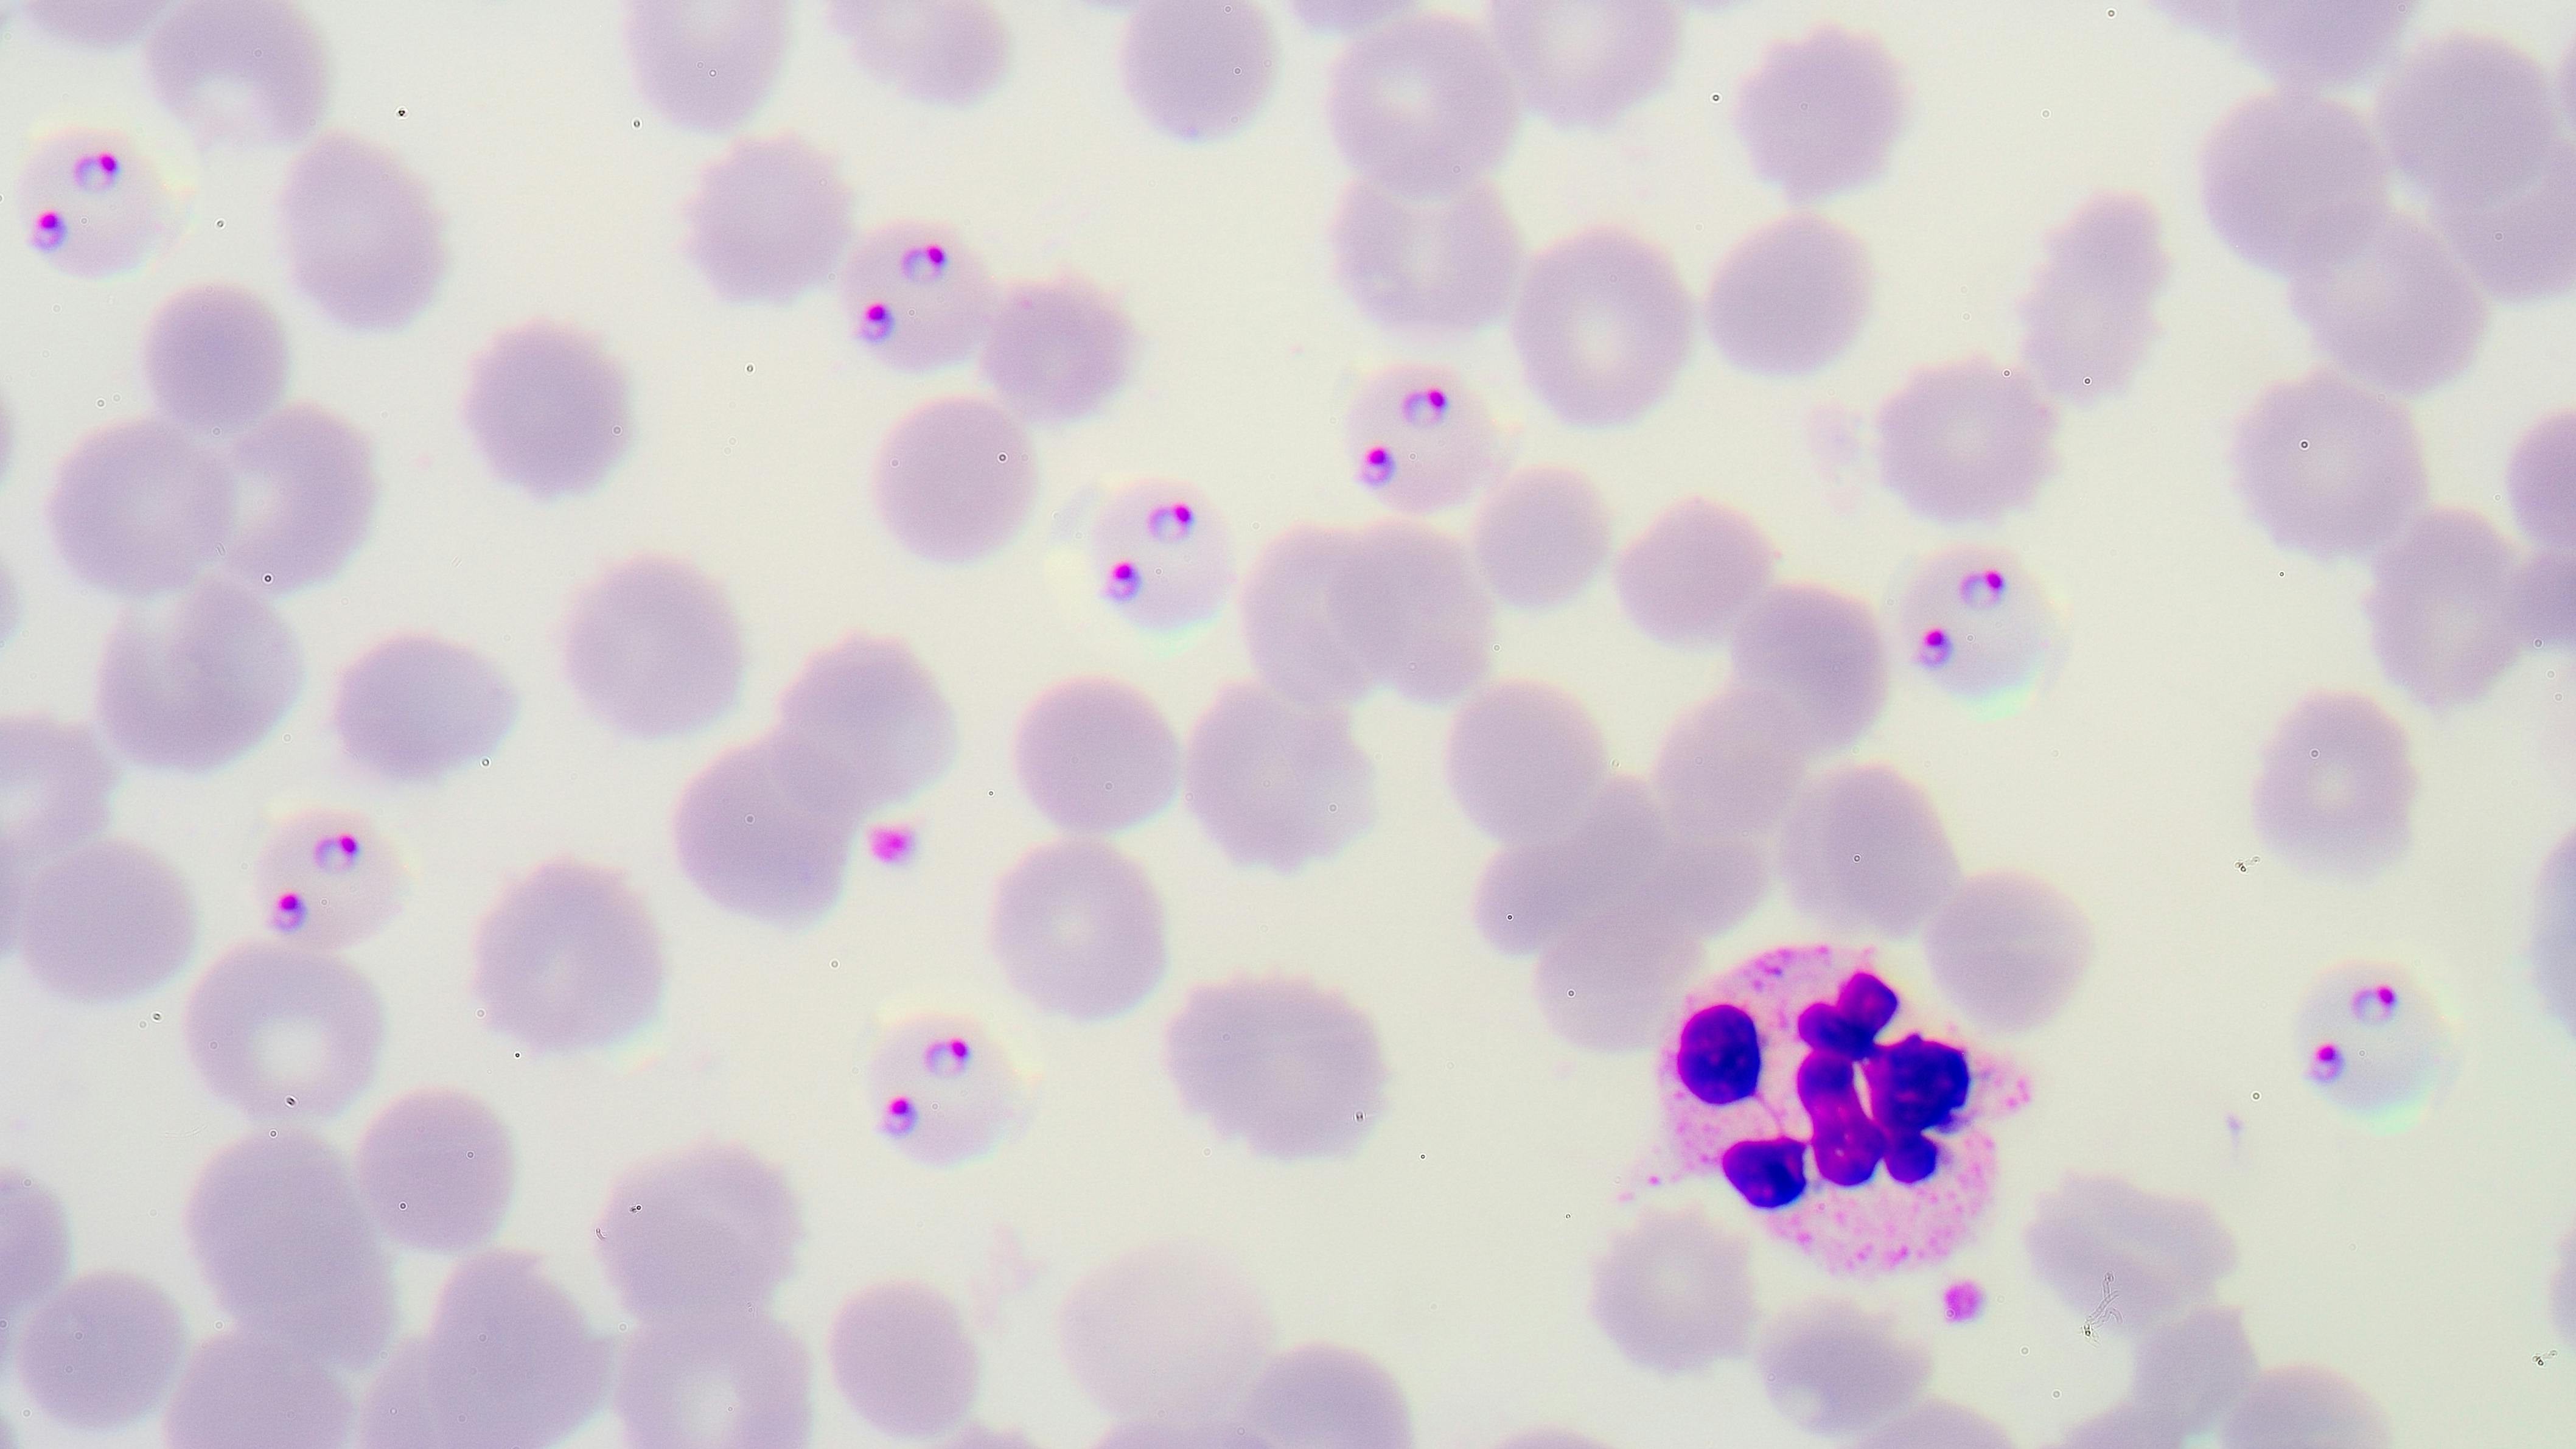
678925b89e95495de2ad1660 Dreamstime Xxl 66537811

The U.S. Food and Drug Administration (FDA) is proposing a draft guidance to minimize the threat of the risk of transfusion-transmitted malaria (TTM).
“Recommendations to Reduce the Risk of Transfusion-Transmitted Malaria,” if finalized, will replace the 2022 guidance.
The revision suggests “selectively testing blood donations from donors at risk for malaria using an FDA-licensed donor screening nucleic acid test (NAT) for Plasmodium species (spp.), the causative agent of malaria,” according to FDA’s announcement. Some of the testing criteria include if the patient has lived in a country with widespread malaria or if the patient has a history of the disease.
The new recommendations do not apply to Source Plasma.
AABB announced that they will be submitting comments to the FDA during the 60-day comment period.